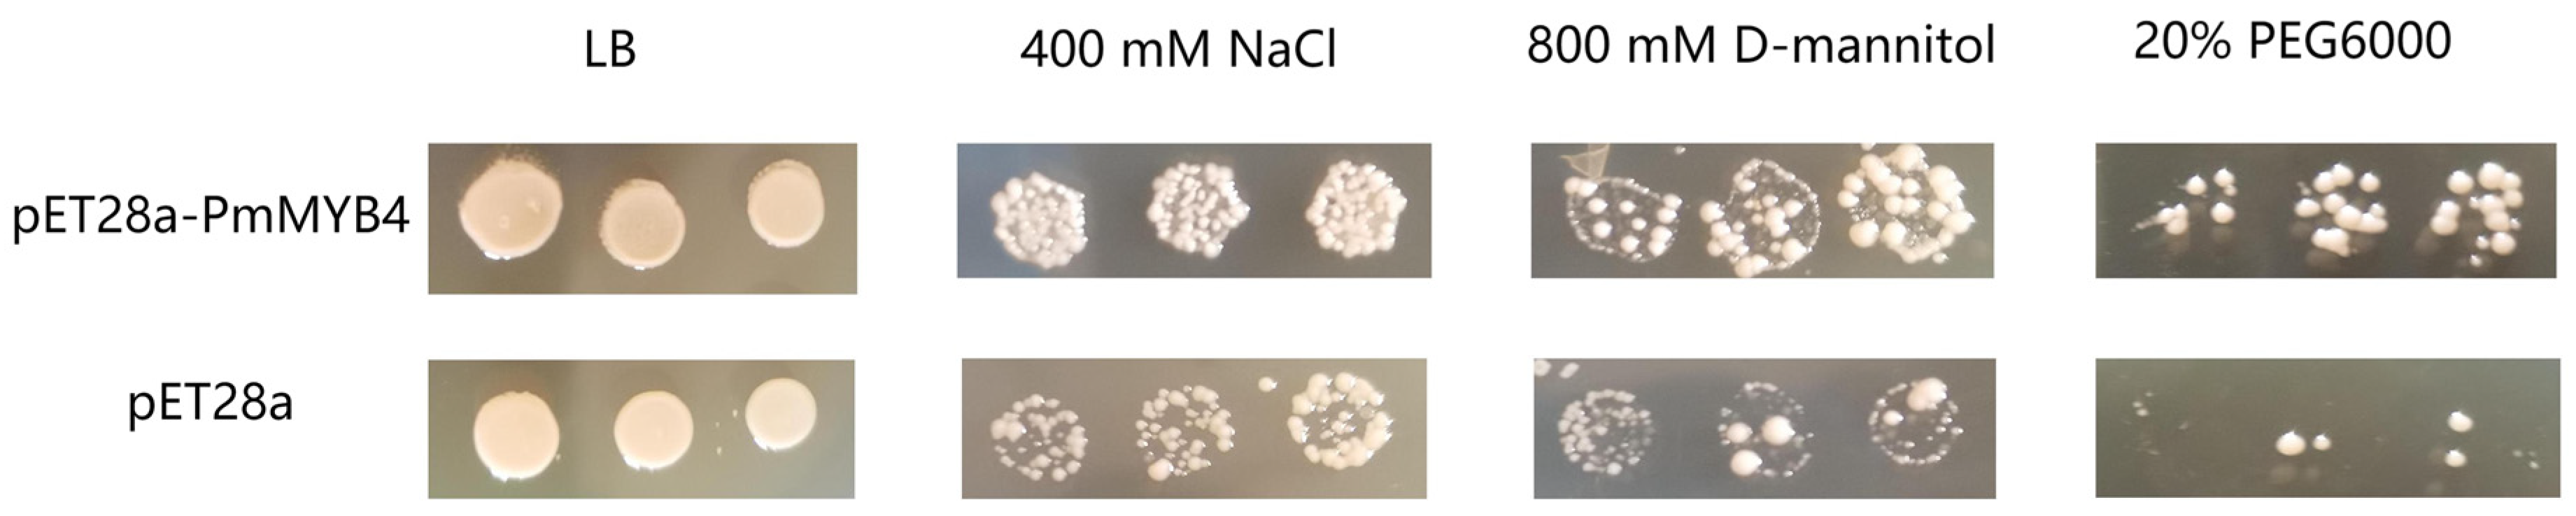
Forests 14 00410 g007 Forests 14 00410 g007

Transcriptome Identification of R2R3-MYB Gene Family Members in Pinus massoniana and PmMYB4 Response to Drought Stress
Abstract
1. Introduction
2. Materials and Methods
2.1. Identification and Classification of R2R3-MYB Genes from Masson Pine
2.2. Characterization of MYB Gene Family Members of Masson Pine
2.3. Phylogenetic Analysis of R2R3-MYB Proteins in Masson Pine
2.4. Expression Pattern Analysis of Masson Pine R2R3-MYB Genes
2.5. Subcellular Localization Detection
2.6. Response of PmMYB4 to Stress
2.7. Gene Expression Analysis and Promoter Cis-Acting Element Analysis of PmMYB4
3. Results
3.1. Identification of R2R3-MYB TF in Masson Pine
3.2. Physical Properties of R2R3-MYB TF in Masson Pine
3.3. Structure Analysis and Motif Composition of Masson Pine R2R3-MYB TF
3.4. Phylogenetic Relationship of Masson Pine R2R3-MYBs
3.5. Expression Profile Analysis of Masson Pine R2R3-MYBs
3.6. Expression Profiles of PmMYB4 under Drought Stress
3.7. Subcellular Localization of PmMYB4
3.8. Response of PmMYB4 to Salt and Drought Stress
3.9. The Expression Patterns of PmMYB4 in Masson Pine
3.10. Promoter Cis-Acting Element Analysis of PmMYB4
3.11. Expression Profiles of PmMYB4 under Abiotic Stress
4. Discussion
5. Conclusions
Supplementary Materials
Author Contributions
Funding
Institutional Review Board Statement
Informed Consent Statement
Data Availability Statement
Acknowledgments
Conflicts of Interest
References
- Niu, Y.L.; Jiang, X.M.; Xu, X.Y. Research progress of plant transcription factor MYB gene family. Mol. Plant Breed 2016, 14, 2050–2059. [Google Scholar]
- Martin, C.; Javier, P.A. MYB transcription factors in plants. Trends Genet 1997, 13, 67–73. [Google Scholar] [CrossRef] [PubMed]
- Du, H.; Tang, X.-F.; Liu, L.; Yang, W.-J.; Wu, Y.-M.; Huang, Y.-B.; Tang, Y.-X. Cloning and functional identification of the two MYB transcription factors GmMYBJ6 and GmMYBJ7 in soybean. Acta Agron. Sin. 2008, 34, 1179–1187. [Google Scholar] [CrossRef]
- Stracke, R.; Werber, M.; Weisshaar, B. The R2R3-MYB gene family in Arabidopsis thaliana. Curr. Opin Plant Biol. 2001, 4, 447–456. [Google Scholar] [CrossRef]
- Katiyar, A.; Smita, S.; Lenka, S.; Rajwanshi, R.; Chinnusamy, V.; Bansal, K. Genome-wide classification and expression analysis of MYB transcription factor families in rice and Arabidopsis. BMC Genomics 2012, 13, 544. [Google Scholar] [CrossRef]
- Liu, L.; Du, H.; Tang, X.F.; Wu, Y.M.; Tang, Y.X. The roles of MYB transcription factors on plant defense responses and its molecular mechanism. Yi Chuan 2008, 10, 1265–1271. [Google Scholar] [CrossRef]
- Zhu, J.K. Abiotic stress signaling and responses in plants. Cell 2016, 167, 313–324. [Google Scholar] [CrossRef]
- Mohammadi, H.; Amirikia, F.; Ghorbanpour, M.; Fatehi, F.; Hashempour, H. Salicylic acid induced changes in physiological traits and essential oil constituents in different ecotypes of Thymus kotschyanus and Thymus vulgaris under well-watered and water stress conditions. Ind. Crops Prod. 2019, 129, 561–574. [Google Scholar] [CrossRef]
- Wang, R.K.; Cao, Z.H.; Hao, Y.J. Overexpression of a R2R3 MYB gene MdSIMYB1 increases tolerance to multiple stresses in transgenic tobacco and apples. Physiol. Plantarum 2014, 150, 76–87. [Google Scholar] [CrossRef]
- Wei, Q.H.; Zhang, F.; Sun, F.S.; Luo, Q.C.; W, R.B. A wheat MYB transcriptional repressor TaMyb1D regulates phenylpropanoid metabolism and enhances tolerance to drought and oxidative stresses in transgenic tobacco plants. Plant Sci. 2017, 265, 112–123. [Google Scholar] [CrossRef]
- Cui, J.; Ning, J.; Zhou, X.; Hou, X.; Yang, G.; Meng, J.; Luan, Y. Tomato MYB49 enhances resistance to Phytophthora infestans and tolerance to water deficit and salt stress. Planta 2018, 248, 1487–1503. [Google Scholar] [CrossRef] [PubMed]
- Gao, F.; Zhou, J.; Deng, R.Y.; Zhao, H.X.; Li, C.L.; Chen, H.; Suzuki, T.; Park, S.U.; Wu, Q. Overexpression of a tartary buckwheat R2R3-MYB transcription factor gene, FtMYB9, enhances tolerance to drought and salt stresses in transgenic Arabidopsis. J. Plant. Physiol. 2017, 214, 81–90. [Google Scholar] [CrossRef] [PubMed]
- Huang, Y.; Zhao, H.; Fei, G.; Yao, P.; Deng, R.; Li, C.; Hui, C.; Qi, W. A R2R3-MYB transcription factor gene, FtMYB13, from Tartary buckwheat improves salt/drought tolerance in Arabidopsis. Plant Physiol. Bioch. 2018, 132, 238–248. [Google Scholar] [CrossRef]
- Alexander, R.D.; Charlotte, W.N.; Morris, P.C. The barley transcription factor HvMYB1 is a positive regulator of drought tolerance. Plant Physiol. Bioch. 2019, 142, 246–253. [Google Scholar] [CrossRef] [PubMed]
- Wu, J.; Jiang, Y.; Liang, Y.; Chen, L.; Chen, W.; Cheng, B. Expression of the maize MYB transcription factor ZmMYB3R enhances drought and salt stress tolerance in transgenic plants. Plant Physiol. Bioch. 2019, 137, 179–188. [Google Scholar] [CrossRef] [PubMed]
- Jiang, Y.; Luo, Q.; Jiang, C.Y.; Sun, G.J.; Nie, Q. Function analysis of tobacco transcription factor NtMYB4a in response to drought, low temperature and methyl jasmonate stress. Crop Sci. 2021, 35, 43–49. [Google Scholar]
- Yuan, Y.; Qi, L.; Yang, J.; Wu, C.; Liu, Y.; Huang, L. A Scutellaria baicalensis R2R3-MYB gene, SbMYB8, regulates flavonoid biosynthesis and improves drought stress tolerance in transgenic tobacco. Plant Cell, Tissue Organ Cult. 2015, 120, 961–972. [Google Scholar] [CrossRef]
- Fang, Q.; Wang, X.; Wang, H.; Tang, X.; Luo, K. The poplar R2R3 MYB transcription factor PtrMYB94 coordinates with abscisic acid signaling toimprove drought tolerance in plants. Tree Physiol. 2020, 40, 46–59. [Google Scholar] [CrossRef]
- Bai, Y.; Zhou, Y.; Gong, J. Physiological mechanisms of the tolerance response to manganese stress exhibited by Pinus massoniana, a candidate plant for the phytoremediation of Mn-contaminated soil. Environ. Sci. Pollut. Res. 2021, 28, 45422–45433. [Google Scholar] [CrossRef]
- Ran, J. Transcriptome analysis of needle and root of Pinus massoniana in response to continuous drought stress. Plants 2021, 10, 769. [Google Scholar]
- Du, M.F.; Ding, G.J.; Zhao, X.Z. Responses to continuous drought stress and drought resistance of different Masson pine families. Scientia Silvae Sinicae 2017, 53, 21–29. [Google Scholar]
- Quan, W.X.; Ding, G.J. Dynamic of volatiles and endogenous hormones in Pinus massoniana needles under drought stress. Scientia Silvae Sinicae 2017, 53, 49–55. [Google Scholar]
- Wang, Q.Z.; Shang, X.W.; Tang, W.W.; Li, H.P.; Wen, X.P.; Fan, F.H. Cloning and low phosphorus tolerance function analysis of PmWRKY164 from Pinus massoniana. Chin. J. Agric. Biotechol. 2019, 27, 1016–1024. [Google Scholar]
- Wu, F.; Sun, X.B.; Zou, B.Z.; Zhu, P.H.; Ji, K.S. Transcriptional analysis of Masson pine (Pinus massoniana) under high CO2 stress. Genes 2019, 10, 804. [Google Scholar] [CrossRef]
- Wang, X.F.; He, W.L.; Cai, W.J.; Ruan, Q.Q.; Pan, T.; Ji, K.S. Analysis on transcriptome sequenced for Pinus massoniana. Mol. Plant Breed. 2013, 11, 385–392. [Google Scholar]
- El-Gebali, S.; Mistry, J.; Bateman, A.; Eddy, S.R.; Luciani, A.; Potter, S.C.; Qureshi, M.; Richardson, L.J.; Salazar, G.A.; Smart, A.; et al. The Pfam protein families database in 2019. Nucleic Acids Res. 2019, 47, D1. [Google Scholar] [CrossRef]
- Chen, Z.; Hu, F.C.; Ruan, C.C.; Fan, H.Y.; Guo, L.J.; Zhang, Z.L. Bioinformatics and gene expression analysis of Pineapple R2R3- MYB gene family. Chin. J. Trop. Crops 2019, 40, 1958–1971. [Google Scholar]
- Fan, F.; Wang, Q.; Wen, X.; Ding, G. Transcriptome-wide identification and expression profiling of Pinus massoniana MYB transcription factors responding to phosphorus deficiency. J. For. Res. 2020, 31, 11. [Google Scholar] [CrossRef]
- Blom, N.; Gammeltoft, S.; Brunak, S. Sequence- and structure-based prediction of eukaryotic protein phosphorylation sites. J. Mol. Biol. 1999, 5, 1351–1362. [Google Scholar] [CrossRef] [PubMed]
- Zhou, F.; Chen, Y.; Wu, H.; Yin, T. Genome-wide comparative analysis of R2R3 MYB gene family in Populus and Salix and identification of male flower bud development-related genes. Front. Plant Sci. 2021, 12, 721558. [Google Scholar] [CrossRef] [PubMed]
- Dubos, C.; Stracke, R.; Grotewold, E.; Weisshaar, B.; Martin, C.; Lepiniec, L. MYB transcription factors in Arabidopsis. Trends Genet. 2010, 15, 573–581. [Google Scholar] [CrossRef] [PubMed]
- Yang, Z. PAML 4, Phylogenetic analysis by maximum likelihood. Mol. Biol. Evol. 2007, 24, 1586–1591. [Google Scholar] [CrossRef]
- Letunic, I.; Bork, P. Interactive Tree Of Life (iTOL) v5: An online tool for phylogenetic tree display and annotation. Nucleic Acids Res. 2021, 49, W1. [Google Scholar] [CrossRef] [PubMed]
- Zhu, P.H.; Ma, Y.Y.; Zhu, L.Z.; Chen, Y.; Li, R.; Ji, K.S. Selection of suitable reference genes in Pinus massoniana Lamb. under different abiotic stresses for qPCR normalization. Forests 2019, 10, 632. [Google Scholar] [CrossRef]
- Livak, K.; Schmittgen, T. Analysis of relative gene expression data using real-time quantitative PCR and the 2−ΔΔCt method. Methods. 2001, 25, 402–408. [Google Scholar] [CrossRef]
- Froidure, S.; Canonne, J.; Danie, X.; Jauneau, A.; Brièr, C.; Roby, D.; Rivas, S.; Baulcombe, D.C. AtsPLA2-alpha nuclear relocalization by the Arabidopsis transcription factor AtMYB30 leads to repression of the plant defense response. Proc. Natl. Acad. Sci. USA 2010, 107, 15281–15286. [Google Scholar] [CrossRef] [PubMed]
- Zhao, C.L.; Peng, L.Y.; Wang, X.; Chen, J.L.; Wang, L.; Chen, H.; Lai, Z.X.; Liu, S.C. Codon bias and evolution analysis of AtGAI in Amaranthus tricolor L. J. China Agric. Univ. 2019, 24, 10–22. [Google Scholar]
- Xue, Y.; Wang, B.; Wang, L. Analysis of codon bias of PaCBF1 gene in Prunus armeniaca L. Mol. Plant Breed 2018, 16, 4890–4898. [Google Scholar]
- Angov, E. Codon usage, Nature’s roadmap to expression and folding of proteins. Biotechnol. J. 2011, 6, 650–659. [Google Scholar] [CrossRef]
- Tuller, T.; Waldman, Y.Y.; Kupiec, M.; Sherman, R.F. Translation efficiency is determined by both codon bias and folding energy. Proc. Natl. Acad. Sci. USA 2010, 107, 3645–3650. [Google Scholar] [CrossRef]
- Shen, Y.; Sun, T.; Pan, Q.; Nachaisin, A.; Ning, G. RrMYB5- and RrMYB10-regulated flavonoid biosynthesis plays a pivotal role in feedback loop responding to wounding and oxidation in Rosa rugosa. Plant Biotechnol. J. 2019, 17, 2078–2095. [Google Scholar] [CrossRef] [PubMed]
- Yang, X.; Li, J.; Guo, T.; Guo, B.; An, X. Comprehensive analysis of the R2R3-MYB transcription factor gene family in Populus trichocarpa. Ind. Crop. Prod. 2021, 168, 113614. [Google Scholar] [CrossRef]
- Du, H.; Yang, S.S.; Liang, Z.; Feng, B.R.; Lei, L.; Huang, Y.B.; Tang, Y.X. Genome-wide analysis of the MYB transcription factor superfamily in Soybean. BMC Plant Biol. 2012, 12, 106. [Google Scholar] [CrossRef] [PubMed]
- Wilkins, O.; Nahal, H.; Foong, J.; Campbell, P. Expansion and diversion of the Populus R2R3-MYB family of transcription factors. Plant Physiol. 2009, 149, 981–993. [Google Scholar] [CrossRef] [PubMed]
- Tombuloglu, H. Genome-wide identification and expression analysis of R2R3,3R- and 4R-MYB transcription factors during lignin biosynthesis in flax(Linum usitatissimum). Genomics 2019, 112, 782–795. [Google Scholar] [CrossRef]
- Chen, Y.H.; Yang, X.Y.; He, K.; Liu, M.H.; Li, J.G.; Gao, Z.F.; Lin, Z.Q.; Zhang, Y.F.; Wang, X.X.; Qiu, X.M.; et al. The MYB transcription factor superfamily of Arabidopsis: Expression analysis and phylogenetic comparison with the rice MYB family. Plant Mol. Biol. 2006, 60, 107–124. [Google Scholar]
- Liu, C.Y.; Hao, J.J.; Qiu, M.Q.; Pan, J.J.; He, Y.H. Genome-wide identification and expression analysis of the MYB transcription factor in Japanese plum (Prunus salicina). Genomics 2020, 112, 4875–4886. [Google Scholar] [CrossRef]
- Liu, C.Y.; Xie, T.; Chen, C.J.; Luan, A.P.; Long, J.M.; Li, C.H.; Ding, Y.Q.; He, Y.H. Genome-wide organization and expression profiling of the R2R3-MYB transcription factor family in Pineapple (Ananas comosus). BMC Genom. 2017, 18, 503. [Google Scholar] [CrossRef]
- Song, W.L.; Xiang, G.S.; Lu, Y.C.; Zhang, G.H.; Yang, S.C.; Zhao, Y. Identification and expression profiling of R2R3-MYB transcription factors in Erigeron breviscapus. CJCMM 2021, 46, 6149–6162. [Google Scholar]
- Song, Y.; Liu, H.D.; Zhang, H.J.; Dou, L.D. Analysis of transcriptome and R2R3-MYB transcription factors in blueberry fruit. Yuan Yi Xue Bao 2015, 42, 2383–2394. [Google Scholar]
- He, Y.Q.; Zhang, X.Y.; Li, L.Y.; Sun, Z.T.; Li, J.M.; Chen, X.Y.; Hong, G.J. SPX4 interacts with both PHR1 and PAP1 to regulate critical steps in phosphorus status-dependent anthocyanin biosynthesis. New Phytol. 2021, 230, 205–217. [Google Scholar] [CrossRef] [PubMed]
- Wu, H.T.; Tian, Y.; Wan, Q.; Fang, L.; Guan, X.Y.; Chen, J.D.; Hu, Y.; Ye, W.X.; Zhang, H.; Guo, W.Z.; et al. Genetics and evolution of MIXTA genes regulating cotton lint fiber development. New Phytol. 2018, 217, 883–895. [Google Scholar] [CrossRef] [PubMed]
- Tohge, T.; Nishiyama, Y.; Hirai, M.Y.; Yano, M.; Nakajima, J.I.; Awazuhara, M.; Inoue, E.; Takahashi, H.; Goodenowe, D.B.; Kitayama, M.; et al. Functional genomics by integrated analysis of metabolome and transcriptome of Arabidopsis plants over-expressing an MYB transcription factor. Plant J. 2005, 42, 218–235. [Google Scholar] [CrossRef] [PubMed]
- Zhou, J.; Lee, C.; Zhong, R.; Ye, Z.H. MYB58 and MYB63 are transcriptional activators of the lignin biosynthetic pathway during secondary cell wall formation in Arabidopsis. Plant Cell. 2009, 21, 248–266. [Google Scholar] [CrossRef] [PubMed]
- Yang, A.; Dai, X.; Zhang, W. A R2R3-type MYB gene, OsMYB2, is involved in salt, cold, and dehydration tolerance in rice. J. Exp. Bot. 2012, 63, 2541–2556. [Google Scholar] [CrossRef] [PubMed]
- Zhang, X.Q.; Dong, B.Y.; Song, Z.H.; Du, T.T.; Li, N.; Xue, J.Y.; Cao, H.Y.; Wang, T.Y.; Song, Y.B.; Meng, D.; et al. Identification of MYB-related subfamily genes in Cajanus cajan and functional analysis of CcMYB-R48 under drought stress. J. Agric. Biotechnol. 2022, 30, 1698–1712. [Google Scholar]
- Cutler, S.R.; Rodriguez, P.L.; Finkelstein, R.R.; Abrams, S.R. Abscisic acid: Emergence of a core signaling network. Annu. Rev. Plant Biol. 2010, 61, 651–679. [Google Scholar] [CrossRef] [PubMed]
- Kawaura, K.; Mochida, K.; Ogihara, Y. Genome-wide analysis for identification of salt-responsive genes in common wheat. Funct. Integr. Genomic. 2008, 8, 277–286. [Google Scholar] [CrossRef] [PubMed]
- Kizis, D.; Lumbreras, V.; Pages, M. Role of AP2/EREBP transcription factors in gene regulation during abiotic stress. Febs Lett. 2001, 498, 187–189. [Google Scholar] [CrossRef]
- Guo, H.; Wu, T.; Li, S.; He, Q.; Deng, H. The methylation patterns and transcriptional responses to chilling stress at the seedling stage in rice. Int. J. Mol. Sci. 2019, 20, 5089–5106. [Google Scholar] [CrossRef]
- Tang, Y.; Bao, X.; Zhi, Y.; Wu, Q.; Guo, Y.R.; Yin, X.H.; Zeng, L.Q.; Li, J.; Zhang, J.; He, W.L. OsMYB6 overexpression of a MYB family gene, increases drought and salinity stress tolerance intransgenic rice. Front. Plant Sci. 2019, 10, 168. [Google Scholar] [CrossRef]
- Li, Z.D.; Chen, Z.C.; Cao, Z.; Che, L.P.; Liu, S.W.; Zhang, Y.T. Xylem anatomical and hydraulic drought resistance characteristics of common tree species in hilly areas of North China. Acta Ecol. Sin. 2021, 41, 69–78. [Google Scholar]
- Geng, D.; Chen, A.P.; Shen, A.X.; Zhang, A.Y.; Li, B.X. MdMYB88 and MdMYB124 enhance drought tolerance by modulating root vessels and cell walls in apple. Plant Physiol. 2018, 178, 1296–1309. [Google Scholar] [CrossRef] [PubMed]
- Yao, S.; Chen, P.Z.; Yu, Y.; Zhang, M.Y.; Wang, D.B.; Liu, J.H.; Hao, Q.Q.; Ji, K.S. PmMYB4, a transcriptional activator from Pinus massoniana, regulates secondary cell wall formation and lignin biosynthesis. Forests 2021, 12, 1618. [Google Scholar] [CrossRef]
- Chen, K.Q.; Song, M.R.; Guo, Y.N.; Liu, L.F.; Xue, H.; Dai, H.Y.; Zhang, Z.H. MdMYB46 could enhance salt and osmotic stress tolerance in apple by directly activating stress-responsive signals. Plant Biotechnol. J. 2019, 17, 2341–2355. [Google Scholar] [CrossRef] [PubMed]
- Wang, Y.M.; Wang, C.; Guo, H.Y.; Wang, Y.C. BplMYB46 from Betula platyphylla can form homodimers and heterodimers and is involved in salt and osmotic stresses. Int. J. Mol. Sci. 2019, 20, 1171. [Google Scholar] [CrossRef] [PubMed]
- Cheng, G.; Wang, L.; Lan, H. Cloning of PEPC-1 from a C4 halophyte Suaeda aralocaspica without Kranz anatomy and its recombinant enzymatic activity in responses to abiotic stresses. Enzyme. Microb. Tech. 2016, 11, 57–67. [Google Scholar] [CrossRef]
- Gong, L.T.; Su, X.J.; Yin, S.S.; Sun, M.H.; Yan, B.W.; Adilai, A.A. Cloning, expression analysis and prokaryotic expression of lavender DXS gene. Xinjiang Agric. Sci. 2020, 7, 1233–1242. [Google Scholar]
- Ambawat, S.; Sharma, P.; Yadav, N.R.; Yadav, R.C. MYB transcription factor genes as regulators for plant responses: An overview. Physiol. Mol. Biol. Pla. 2013, 19, 307–321. [Google Scholar] [CrossRef]
- Xiong, H.; Yu, J.; Miao, J.; Li, J.; Zhang, H.; Xin, W.; Liu, P.; Yan, Z.; Jiang, C.; Yin, Z. Natural variation in OsLG3 increases drought tolerance in rice by inducing ROS scavenging. Plant Physiol. 2018, 178, 451–467. [Google Scholar] [CrossRef]
- Ramírez, V.; Agorio, A.; Coego, A.; Javier, G.A.; Hernández, M.J.; Balaguer, B.; Ouwerkerk, P.B.; Zarra, I.; Vera, P. MYB46 modulates disease susceptibility to Botrytis cinerea in Arabidopsis. Plant Physiol. 2011, 155, 1920–1935. [Google Scholar] [CrossRef] [PubMed]

Disclaimer/Publisher’s Note: The statements, opinions and data contained in all publications are solely those of the individual author(s) and contributor(s) and not of MDPI and/or the editor(s). MDPI and/or the editor(s) disclaim responsibility for any injury to people or property resulting from any ideas, methods, instructions or products referred to in the content. |
© 2023 by the authors. Licensee MDPI, Basel, Switzerland. This article is an open access article distributed under the terms and conditions of the Creative Commons Attribution (CC BY) license (https://creativecommons.org/licenses/by/4.0/).
Share and Cite
Lou, X.; Yao, S.; Chen, P.; Wang, D.; Agassin, R.H.; Hou, Y.; Zhang, C.; Ji, K. Transcriptome Identification of R2R3-MYB Gene Family Members in Pinus massoniana and PmMYB4 Response to Drought Stress. Forests 2023, 14, 410. https://doi.org/10.3390/f14020410
Lou X, Yao S, Chen P, Wang D, Agassin RH, Hou Y, Zhang C, Ji K. Transcriptome Identification of R2R3-MYB Gene Family Members in Pinus massoniana and PmMYB4 Response to Drought Stress. Forests. 2023; 14(2):410. https://doi.org/10.3390/f14020410
Chicago/Turabian StyleLou, Xuan, Sheng Yao, Peizhen Chen, Dengbao Wang, Romaric Hippolyte Agassin, Yanqing Hou, Chi Zhang, and Kongshu Ji. 2023. "Transcriptome Identification of R2R3-MYB Gene Family Members in Pinus massoniana and PmMYB4 Response to Drought Stress" Forests 14, no. 2: 410. https://doi.org/10.3390/f14020410
APA StyleLou, X., Yao, S., Chen, P., Wang, D., Agassin, R. H., Hou, Y., Zhang, C., & Ji, K. (2023). Transcriptome Identification of R2R3-MYB Gene Family Members in Pinus massoniana and PmMYB4 Response to Drought Stress. Forests, 14(2), 410. https://doi.org/10.3390/f14020410





